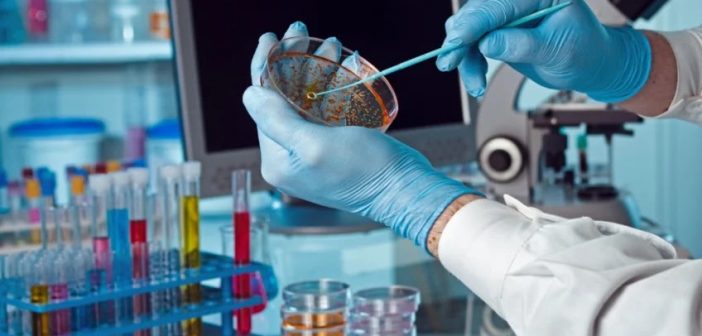

Ανησυχία προκαλεί στους επιστήμονες η ραγδαία εξάπλωση της υποπαραλλαγής «Eris» και στην χώρα μας. Το στέλεχος της EG.5.1 που ανιχνεύθηκε για πρώτη φορά τον Μάιο στην Κρήτη εντοπίζεται πλέον στο 69% των δειγμάτων στην Kρήτη ανέφερε στο protothema.gr o καθηγητής του Πανεπιστημίου Κρήτης και Διευθυντής της Πνευμονολογικής Κλινικής του ΠΑΓΝΗ, Νίκος Τζανάκης.
Η νέα αυτή μετάλλαξη έχει ήδη ανιχνευθεί ήδη σε 45 χώρες του κόσμου, και είναι ιδιαίτερα μεταδοτική όπως αναφέρουν οι υγειονομικές αρχές από Ιαπωνία, Βρετανία και Αμερική. Ο κ. Τζανάκης εκτιμά ότι η εξαρση αυτή πιθανότατα να συνδέεται και από το γεγονός ότι η κοινότητα έχει απομακρυνθεί από το εμβολιαστικό πρόγραμμα για τον κορωνοϊό και απευθύνει έκκληση ιδίως για τους ευάλωτους να είναι ιδιαίτερα προσεκτικοί και αν είναι δυνατόν να επαναφέρουν την καθημερινή χρήση της μάσκας και την τήρηση των αποστάσεων. Παράλληλα ανέφερε ότι θα πρέπει να συνταγογραφούνται έγκαιρα τα αντιικά φάρμακα.
«Η νέα παραλλαγή ERIS εγείρει ανησυχίες για έναν δύσκολο χειμώνα» δήλωσε χαρακτηριστικά ο κ. Τζανάκης στο protothema.gr εξηγώντας ότι τα κυριότερα συμπτώματα της νόσου είναι ο πονόλαιμος, έντονη καταρροή, πυρετός για 1-2 ημέρες και κόπωση για 1-2 ημέρες.
H Κρήτη, όπως είναι γνωστό, δέχεται μεγαλύτερο φορτίο κορωνοϊού λόγω του τουρισμού, ωστόσο όπως εκτιμά ο κ. Τζανάκης ανάλογα θα είναι τα ποσοστά της ERIS και στην υπόλοιπη Ελλάδα.
Οι ανησυχίες των επιστημόνων αφορούν και τις επιπτώσεις που θα υπάρξουν στην κοινότητα στα μέσα Σεπτεμβρίου με το άνοιγμα των σχολείων.
Σύμφωνα με την τελευταία επιδημιολογική έκθεση του ΕΟΔΥ (για το διάστημα από τις 24 έως τις 30 Ιουλίου), η θετικότητα στο σύνολο των ελεγχθέντων δειγμάτων παρουσίασε αύξηση σε σχέση με την προηγούμενη εβδομάδα, όπως και ο αριθμός των εισαγωγών (41% σε σχέση με τον μέσο εβδομαδιαίο αριθμό νέων εισαγωγών κατά τις προηγούμενες 4 εβδομάδες).